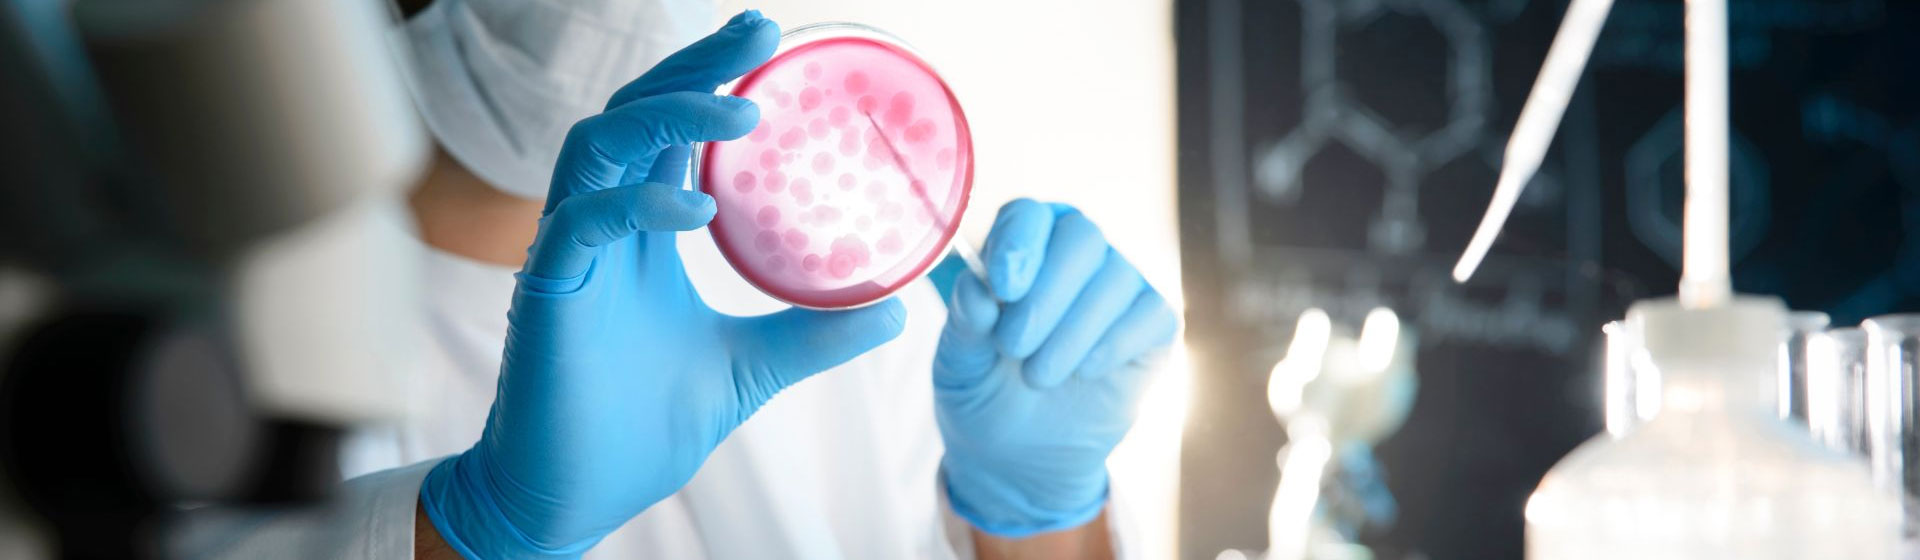
Lời cảm ơn

Lời cảm ơn
Lời cảm ơn
Kính gửi Quý Khách Hàng!
CÔNG TY CỔ PHẦN THIẾT BỊ Y TẾ MEDITECH VIỆT NAM xin gửi ến Quý Khách Hàng lời cảm ơn chân thành và sâu sắc nhất. Chúng tôi vô cùng trân trọng sự tin tưởng và ồng hành mà Quý Khách Hàng đã dành cho Meditech Việt Nam trong suốt thời gian qua.
Nhờ có sự ủng hộ và góp ý quý báu từ Quý Khách Hàng, chúng tôi đã có cơ hội không ngừng hoàn thiện, nâng cao chất lượng sản phẩm và dịch vụ để phục vụ tốt nhất nhu cầu của thị trường. Mỗi sự hợp tác không chỉ là niềm vinh dự lớn lao mà còn là nguồn cảm hứng để chúng tôi tiếp tục sáng tạo, đổi mới và mang lại những giá trị bền vững cho cộng đồng y tế.
Meditech Việt Nam luôn cam kết mang đến những sản phẩm và giải pháp y tế tiên tiến, với chất lượng vượt trội, đáp ứng tốt nhất mọi yêu cầu khắt khe của Quý Khách Hàng. Sự hài lòng và thành công của Quý Khách Hàng chính là thước đo quan trọng nhất cho sự phát triển của chúng tôi.
Chúng tôi hiểu rằng, sự tín nhiệm mà Quý Khách Hàng dành cho Meditech Việt Nam không chỉ là một cơ hội mà còn là trách nhiệm lớn lao. Vì vậy, toàn thể đội ngũ nhân sự của Meditech Việt Nam luôn nỗ lực hết mình để duy trì và nâng cao chất lượng sản phẩm, dịch vụ, đồng thời xây dựng mối quan hệ hợp tác bền vững, lâu dài.
Một lần nữa, Meditech Việt Nam xin chân thành cảm ơn sự đồng hành, ủng hộ và tin tưởng của Quý Khách Hàng. Chúng tôi mong tiếp tục nhận ược sự quan tâm và hợp tác từ Quý Khách Hàng trong thời gian tới, để cùng nhau góp phần vào sự phát triển của ngành y tế Việt Nam.
Trân trọng
Công Ty Cổ Phần Thiết Bị Y Tế Meditech Việt Nam



